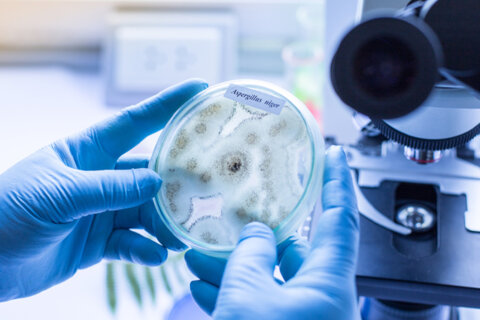

Дисциплины по выбору

Для студентов 2 курса, 4 семестр
Специальность 36.05.01 - Ветеринария (болезни продуктивных животных)


Для студентов 2 курса специальность 36.05.01 - Ветеринария (Лабораторное дело)
- Преподаватель: Саражакова Ирина Михайловна
- Преподаватель: Колесников Владимир Алексеевич
- Преподаватель: Колесников Владимир Алексеевич
- Преподаватель: Сулайманова Гульнара Владимировна

Для студентов 2 курса, 4 семестр
специальности 36.05.01 - Ветеринария (Болезни непродуктивных животных)

- Преподаватель: Мороз Анастасия Анатольевна
- Преподаватель: Колосова Ольга Валериевна

Кафедра Эпизоотологии, микробиологии, паразитологии и ВСЭ
Специальность: 36.05.01 Ветеринария
Специализации: «Ветеринарная фармация»
Курс: 5 очное отделение, 6 заочное отделение
Автор-составитель: Немкова Наталья Павловна, к.в.н., доцент
- Преподаватель: Мороз Анастасия Анатольевна

36.05.01 – Ветеринария, специализация "Болезни непродуктивных животных"
Форма обучения: очная, курс - 3; семестр - 5
Кафедра эпизоотологии, микробиологии, паразитологии и ВСЭ
Автор-составитель: к.в.н., доцент Щербак О.И.
- Преподаватель: Щербак Ольга Ивановна

36.05.01 – Ветеринария, специализация "Лабораторное дело"
Форма обучения: очная, курс - 5; семестр - 10
Кафедра эпизоотологии, микробиологии, паразитологии и ВСЭ
Автор-составитель: к.в.н., доцент Щербак О.И.
- Преподаватель: Щербак Ольга Ивановна

- Преподаватель: Счисленко Светлана Анатольевна


- Преподаватель: Мороз Анастасия Анатольевна
- Преподаватель: Счисленко Светлана Анатольевна

Для студентов 2 курса специальности 36.05.01 - Ветеринария
- Преподаватель: Гавриленко Ирина Владимировна
- Преподаватель: Саражакова Ирина Михайловна
- Преподаватель: Петрова Элина Анатольевна
Институт прикладной биотехнологии и ветеринарной медицины
36.03.02 Зоотехния для заочной формы обучения
- Преподаватель: Сулайманова Гульнара Владимировна
- Преподаватель: Петрова Элина Анатольевна
- Преподаватель: Петрова Элина Анатольевна

- Преподаватель: Сулайманова Гульнара Владимировна

Институт прикладной биотехнологии и ветеринарной медицины
Для специальности 36.05.01 - Ветеринария
Кафедра внутренних незаразных болезней, акушерства, физиологии с.-х. животных
Форма обучения: очная, 1 курс, 1 семестр
Автор-составитель: Усова И.А.
36.05.01 Ветеринария
- Преподаватель: Саражакова Ирина Михайловна

36.05.01 Ветеринария

Институт прикладной биотехнологии и ветеринарной медицины
36.05.01 Ветеринария
Кафедра внутренних незаразных болезней, акушерства, физиологии с.-х. животных
Форма обучения: очная, 1 курс, 1 семестр
Автор-составитель: Усова И.А.
36.05.01 Ветеринария
- Преподаватель: Петрова Элина Анатольевна
для 36.05.01
- Преподаватель: Мороз Анастасия Анатольевна

36.05.01 Ветеринария
Институт прикладной биотехнологии и ветеринарной медицины
Кафедра: анатомии, патологической анатомиии хирургии
Специальность: 36.05.01 - Ветеринария
Квалификация: ветеринарный врач
Форма обучения очная: курс 5, семестр 10
Форма обучения заочная: курс 5, семестр 10
Автор-составитель: к.в.н., доцент Вахрушева Т.И.

Курс предназначен для студентов направленности: Болезни непродуктивных животных; Болезни продуктивных животных; Лабораторное дело.
Автор составитель - Колосова Ольга Валериевна

Для обучающихся по специальности 36.05.01 Ветеринария
Квалификация: ветеринарный врач
Форма обучения: очная 3 курс, 5 семестр
Автор-составитель: к.в.н., доцент Счисленко С.А.
Кафедра Эпизоотологии, микробиологии, паразитология и ВСЭ
Институт прикладной биотехнологии и ветеринарной медицины
Институт прикладной биотехнологии и ветеринарной медицины
Кафедра: анатомии, патологической анатомии и хирургии
Специальность: 36.05.01 - Ветеринария
Специализация: лабораторное дело
Квалификация: ветеринарный врач
Форма обучения: очная
Курс: 3
Семестр: 5
Автор-составитель: к.в.н., доцент Вахрушева Т.И.
- Преподаватель: Вахрушева Татьяна Ивановна

Для студентов очного и заочного обучения специальности 36.05.01 "Ветеринария"

Для студентов специальности 36.05.01 Ветеринария
Профиль: "Болезни непродуктивных животных"

Для студентов очной и заочной формы обучения специальности 36.05.01 "Ветеринария"

Для студентов 2 курса специальности 36.05.01 Ветеринария
Профиль "Болезни продуктивных животных"
- Преподаватель: Гавриленко Ирина Владимировна

Для студентов специальности 36.05.01 - Ветеринария
36.05.01 Ветеринария

Институт прикладной биотехнологии и ветеринарной медицины
36.05.01 Ветеринария
Кафедра внутренних незаразных болезней, акушерства, физиологии с.-х. животных
Форма обучения: очная, 1 курс, 1 семестр
Автор-составитель: Усова И.А.
- Преподаватель: Усова Ирина Анатольевна
для 36.05.01

Курс предназначен для студентов очного и заочного обучения специальности 36.05.01. "Ветеринария"
- Преподаватель: Гавриленко Ирина Владимировна
